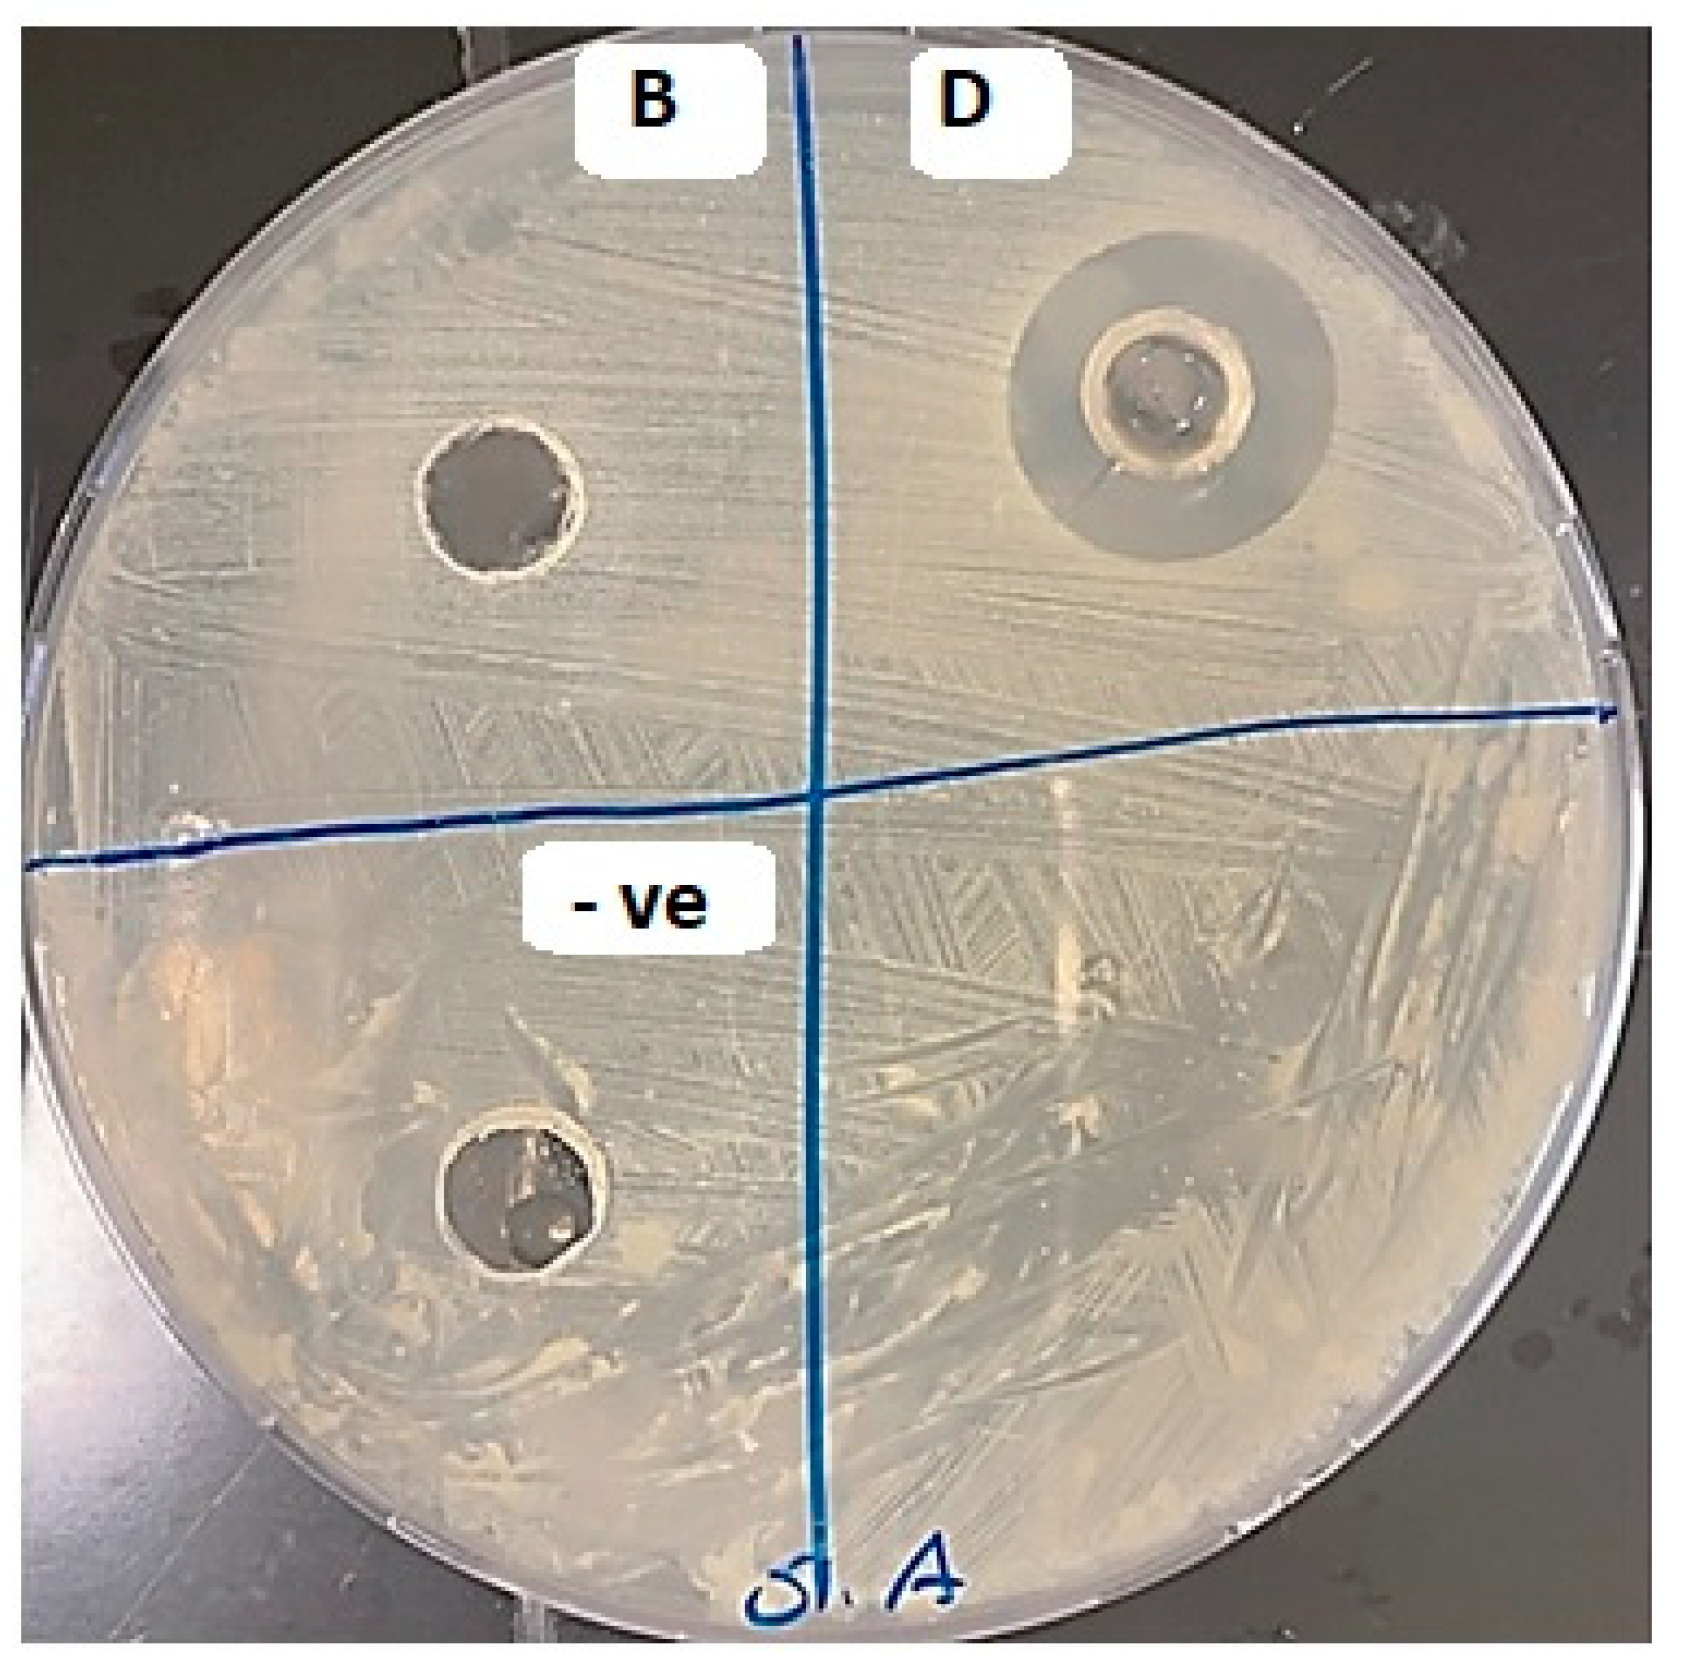
Gels 09 00855 g007

Formulation and In Vivo Evaluation of Biofilm Loaded with Silver Sulfadiazine for Burn Healing
Abstract
:1. Introduction
2. Results and Discussion
2.1. Experimental Design
2.1.1. The Effect on the Mechanical Properties of Dermal Films Containing SSD
2.1.2. The Effect on the In Vitro SSD Release from Dermal Films
2.2. Swelling Index Study
2.3. Release Kinetics
2.4. Optimization of Formulation Parameters
2.5. Differential Scanning Calorimetry (DSC)
2.6. X-ray Powder Diffraction (XRPD)
2.7. Analysis of the Antibacterial Activity of SDD Film
2.7.1. Analysis of the Antibacterial Activity of SSD Film Using Agar Diffusion
2.7.2. Analysis of the Antibacterial Activity of SSD Film in Liquid Culture
2.8. Burn Wound Healing Measurement
2.9. Histopathological Analysis
3. Conclusions
4. Materials and Methods
4.1. Materials
4.2. Experimental Design
4.3. Preparation of Film Loaded with SSD
4.4. Mechanical Properties
4.5. Assessment of Swelling
4.6. In Vitro Drug Release
4.7. Release Kinetics
4.8. Differential Scanning Calorimetry (DSC)
4.9. X-ray Powder Diffraction
4.10. Antibacterial Activity
4.10.1. Analysis of the Antibacterial Activity of SSD Film in Liquid Culture
4.10.2. Analysis of the Antibacterial Activity of SSD Film Using Agar Diffusion
4.11. In Vivo Burn Healing Activity
4.11.1. Animals
4.11.2. Experimental Design
4.12. Histopathological Analysis
4.13. Statistical Analysis
Author Contributions
Funding
Institutional Review Board Statement
Informed Consent Statement
Data Availability Statement
Acknowledgments
Conflicts of Interest
References
- WHO, Burns. Available online: https://www.who.int/news-room/fact-sheets/detail/burns#:~:text=A%20burn%20is%20an%20injury,hot%20liquids%20(scald) (accessed on 1 August 2023).
- Williams, F.N.; Herndon, D.N.; Hawkins, H.K.; Lee, J.O.; Cox, R.A.; Kulp, G.A.; Finnerty, C.C.; Chinkes, D.L.; Jeschke, M.G. The leading causes of death after burn injury in a single pediatric burn center. Crit. Care 2009, 13, R183. [Google Scholar] [CrossRef]
- Saranya, T.V.; Manoj, K. Formulation, Evaluation and Optimization of Novel Silver Sulfadiazine Loaded Film Forming Hydrogel For Burns. Hygeia. J. D. Med. 2016, 8, 1–10. [Google Scholar]
- Azevedo, E.P.; Saldanha, T.D.; Navarro, M.V.; Medeiros, A.C.; Ginani, M.F.; Ran, F.N. Mechanical properties and release studies of chitosan films impregnated with silver sulfadiazine. J. Appl. Polym. Sci. 2006, 102, 3462–3470. [Google Scholar] [CrossRef]
- Homann, H.H.; Rosbach, O.; Moll, W.; Vogt, P.M.; Germann, G.; Hopp, M.; Langer-Brauburger, B.; Reimer, K.; Steinau, H.U. A Liposome Hydrogel with Polyvinyl-Pyrrolidone Iodine in the Local Treatment of Partial Thickness Burn Wounds. Ann. Plast. Surg. 2007, 59, 423–427. [Google Scholar] [CrossRef]
- Huang, Y.; Li, X.; Liao, Z.; Zhang, G.; Liu, Q.; Tang, J.; Peng, Y.; Liu, X.; Luo, Q. A randomized comparative trial between Acticoat and SD-Ag in the treatment of residual burn wounds, including safety analysis. Burns 2007, 33, 161–166. [Google Scholar] [CrossRef]
- Fajardo, A.R.; Lopes, L.C.; Caleare, A.O.; Britta, E.A.; Nakamura, C.V.; Rubira, A.F.; Muniz, E.C. Silver sulfadiazine loaded chitosan/chondroitin sulfate films for a potential wound dressing application. Mater. Sci. Eng. C 2013, 33, 588–595. [Google Scholar] [CrossRef] [PubMed]
- Yassue-Cordeiro, P.H.; Zandonai, C.H.; Genesi, B.P.; Lopes, P.S.; Sanchez-Lopez, E.; Garcia, M.L.; Fernandes-Machado, N.R.C.; Severino, P.; Souto, E.B.; da Silva, C.F. Development of Chitosan/Silver Sulfadiazine/Zeolite Composite Films for Wound Dressing. Pharmaceutics 2019, 11, 535. [Google Scholar] [CrossRef] [PubMed]
- Hong, H.J.; Jin, S.E.; Park, J.S.; Ahn, W.S.; Kim, C.H. Accelerated wound healing by smad3 antisense oligonucleotides impregnated chitosan/alginate polyelectrolyte complex. Biomaterials 2008, 29, 4831–4837. [Google Scholar] [CrossRef]
- Shy, O.; Wu, J.; Moochala, S.H.; Tan, M.H.; Lu, J. Development of a chitosan-based wound dressing with improved hemostatic and antimicrobial properties. Biomaterials 2008, 29, 4323–4332. [Google Scholar] [CrossRef]
- Khubiev, O.M.; Egorov, A.R.; Kirichuk, A.A.; Khrustalev, V.N.; Tskhovrebov, A.G.; Kritchenkov, A.S. Chitosan-Based Antibacterial Films for Biomedical and Food Applications. Int. J. Mol. Sci. 2023, 24, 10738. [Google Scholar] [CrossRef] [PubMed]
- Misra, S.K.; Pathak, K. Chapter 3—Microscale and nanoscale chitosan-based particles for biomedical use. In Chitosan in Biomedical Applications; Hasnain, M.S., Beg, S., Nayak, A.K., Eds.; Academic Press: Cambridge, MA, USA, 2022; pp. 37–73. [Google Scholar]
- Paul, W.; Sharma, C.P. Chitosan and alginate wound dressings: A short review. Trends Biomater. Artif. Organs. 2004, 18, 18–23. [Google Scholar]
- Landsdown, A. Calcium: A potential central regulator in wound healing in the skin. Wound Repair Regen. 2002, 10, 271–285. [Google Scholar] [CrossRef] [PubMed]
- Stenvik, J.; Sletta, H.; Grimstad, Ø.; Pukstad, B.; Ryan, L.; Aune, R.; Strand, W.; Tøndervik, A.; Torp, S.H.; Skjåk-Braek, G.; et al. Alginates induce differentiation and expression of CXCR7 and CXCL12/SDF-1 in human keratinocytes—The role of calcium. J. Biomed. Mater. Res. A 2012, 100, 2803–2812. [Google Scholar] [CrossRef] [PubMed]
- Wang, T.; Gu, Q.; Zhao, J.; Mei, J.; Shao, M.; Pan, Y.; Zhang, J.; Wu, H.; Zhang, Z.; Liu, F. Calcium alginate enhances wound healing by up-regulating the ratio of collagen types I/III in diabetic rats. Int. J. Clin. Exp. Pathol. 2015, 8, 6636–6645. [Google Scholar] [PubMed]
- El-Feky, G.S.; El-Banna, S.T.; El-Bahy, G.S.; Abdelrazek, E.M.; Kamal, M. Alginate coated chitosan nanogel for the controlled topical delivery of Silver sulfadiazine. Carbohydr. Polym. 2017, 1, 194–202. [Google Scholar] [CrossRef]
- Stojkovska, J.; Djurdjevic, Z.; Jancic, I.; Bufan, B.; Milenkovic, M.; Jankovic, R.; Miskovic-Stankovic, V.; Obradovic, B. Comparative in vivo evaluation of novel formulations based on alginate and silver nanoparticles for wound treatments. J. Biomater. Appl. 2018, 32, 1197–1211. [Google Scholar] [CrossRef]
- Kumar, M.N.R. A review of chitin and chitosan applications. React. Funct. Polym. 2000, 46, 1–27. [Google Scholar] [CrossRef]
- Koga, A.Y.; Felix, J.C.; Silvestre, R.G.M.; Lipinski, L.C.; Carletto, B.; Kawahara, F.A.; Pereira, A.V. Evaluation of wound healing effect of alginate film containing Aloe vera gel and cross-linked with zinc chloride. Acta Cir. Bras. 2020, 35, e202000507. [Google Scholar] [CrossRef]
- Nair, A.B.; Kumria, R.; Harsha, S.; Attimarad, M.; Al-Dhubiab, B.E.; Alhaider, I.A. In vitro techniques to evaluate buccal films. J. Cont. Rel. 2013, 28, 10–21. [Google Scholar] [CrossRef]
- Peh, K.K.; Wong, C.F. Polymeric films as a vehicle for buccal delivery: Swelling, mechanical, and bioadhesive properties. J. Pharm. Sci. 1999, 2, 53–61. [Google Scholar]
- Pagano, C.; Ceccarini, M.R.; Calarco, P.; Scuota, S.; Conte, C.; Primavilla, S.; Ricci, M.; Perioli, L. Bioadhesive polymeric films based on usnc acid for burn wound treatment: Antibacterial and cytotoxicity studies. Colloids Surf. B Biointerfaces 2019, 178, 488–499. [Google Scholar] [CrossRef] [PubMed]
- Yan, X.-L.; Khor, E.; Lim, L.-Y. Chitosan-Alginate Films Prepared with Chitosans of Different Molecular Weights. J. Biomed Mater. Res. A 2001, 58, 358–365. [Google Scholar] [CrossRef] [PubMed]
- Li, K.J.; Zhu, J.X.; Guan, G.L.; Wu, H. Preparation of chitosan-sodium alginate films through layer-by-layer assembly and ferulic acid crosslinking: Film properties, characterization, and formation mechanism. Int. J. Biol. Macromol. 2019, 122, 485–492. [Google Scholar] [CrossRef]
- Tapia, C.; Ormazabal, V.; Costa, E.; Yazdani-Pedram, M. Study of dissolution behavior of matrices tablets based on alginate-gelatin mixtures as prolonged diltiazem hydrochloride release systems. Drug Dev. Ind. Pharm. 2007, 33, 585–593. [Google Scholar] [CrossRef]
- Saravanakumar, K.; Thulluru, A.; Samineni, R.; Ishwarya, M.; Nagaveni, P.; Mahammed, N. Effect of Sodium Alginate in Combination with Natural and Synthetic Polymers on the Release of Verapamil HCL from its Floating Microspheres. J. Pharm. Sci. Res. 2019, 11, 2028–2035. [Google Scholar]
- Korsmeyer, R.W.; Gurny, R.; Doelker, E.; Buri, P.; Peppas, N.A. Mechanisms of solute release from porous hydrophilic polymers. Int. J. Pharm. 1983, 15, 25–35. [Google Scholar] [CrossRef]
- Korsmeyer, R.W.; Peppas, N.A. Macromolecular and modeling aspects of swelling controlled systems. In Controlled Release Delivery Systems; Roseman, T.J., Mansdorf, S.Z., Eds.; Dekker: New York, NY, USA, 1983; pp. 77–101. [Google Scholar]
- Mahrous, G.M.; Ibrahim, M.A.; El-Badry, M.; Al-Anazi, F.K. Indomethacin sustained release pellets prepared by extrusion-spheronization. J. Drug Delivery Sci. Technol. 2010, 20, 119–125. [Google Scholar] [CrossRef]
- Janssens, S.; Anné, M.; Rombaut, P.; Van den Mooter, G. Spray drying from complex solvent systems broadens the applicability of Kollicoat IR as a carrier in the formulation of solid dispersions. Eur. J. Pharm. Sci. 2009, 28, 241–248. [Google Scholar] [CrossRef]
- Greenhalgh, D.G.; Sprugel, K.H.; Murray, M.J.; Ross, R. PDGF and FGF stimulate wound healing in the genetically diabetic mouse. Am. J. Pathol. 1990, 136, 1235–1246. [Google Scholar] [PubMed]
- Nachiappan, S.; Amanuel, L.; Agazie, T.; Bihonegn, S. Development and characterization of silk films for burn wound healing. Res. J. Text. Appar. 2020, 24, 131–146. [Google Scholar] [CrossRef]

| Tensile Strength (Mpa); Y1 | Source | Sum of Squares | F-Ratio | p-Value |
| A-CS | 12.91 | 10.46 | 0.0481 | |
| B-SA | 13.80 | 11.18 | 0.0442 | |
| AB | 0.9025 | 0.7314 | 0.4553 | |
| A2 | 0.1422 | 0.1153 | 0.7566 | |
| B2 | 0.0139 | 0.0113 | 0.9222 | |
| Extension at Break Load (mm); Y2 | A-CS | 6.41 | 17.10 | 0.0257 |
| B-SA | 8.40 | 22.42 | 0.0179 | |
| AB | 0.0225 | 0.0600 | 0.8222 | |
| A2 | 0.3200 | 0.8540 | 0.4236 | |
| B2 | 0.2450 | 0.6538 | 0.4779 | |
| In Vitro Release after 30 min (%); Y3 | A-CS | 74.42 | 1.76 | 0.3395 |
| B-SA | 14.61 | 0.3466 | 0.5974 | |
| AB | 9.18 | 0.2177 | 0.6726 | |
| A2 | 35.14 | 0.8334 | 0.4286 | |
| B2 | 40.49 | 0.9602 | 0.3994 | |
| In Vitro Release after 360 min (%); Y4 | A-CS | 272.67 | 6.47 | 0.0845 |
| B-SA | 3.30 | 0.1263 | 0.7458 | |
| AB | 8.08 | 0.3092 | 0.6169 | |
| A2 | 34.88 | 1.33 | 0.3317 | |
| B2 | 133.35 | 5.10 | 0.1091 |
| Formulation | Average TS (Mpa) | Average EB (mm) | Average Thickness (mm) | Folding Endurance | Swelling Index (%) |
|---|---|---|---|---|---|
| F1 | 1.8 ± 0.041 | 3.2 ± 0.400 | 0.7 ± 0.007 | 11 ± 1.0414 | 2.312 ± 0.087 |
| F2 | 5.4 ± 0.228 | 4.9 ± 0.410 | 0.9 ± 0.021 | 24 ± 1.412 | 3.712 ± 0.364 |
| F3 | 0.4 ± 0.046 | 1.7 ± 0.082 | 0.9 ± 0.134 | 7.5 ± 0.707 | 3.002 ± 0.194 |
| F4 | 5.2 ± 0.117 | 5.1 ± 0.483 | 0.6 ± 0 | 25.5 ± 0.709 | 3.307 ± 0.178 |
| F5 | 2.5 ± 0.347 | 3.5 ± 0.683 | 0.6 ± 0.014 | 14.5 ± 1.414 | 2.911 ± 0.116 |
| F6 | 0.7 ± 0.146 | 1.4 ± 0.093 | 0.4 ± 0.021 | 13 ± 0.709 | 3.547 ± 0.600 |
| F7 | 2.2 ± 0.649 | 3 ± 0.687 | 0.6 ± 0.062 | 13.5 ± 1.412 | 3.936 ± 0.073 |
| F8 | 4.5 ± 0.224 | 3.9 ± 0.765 | 0.6 ± 0.021 | 17 ± 2.121 | 2.165 ± 0.566 |
| F9 | 0.6 ± 0.022 | 1.2 ± 1.722 | 0.6 ± 0.035 | 13.5 ± 1.414 | 3.768 ± 0.419 |
| Formula | Zero-Order Model | First-Order Model | Higuchi Diffusion Model | Korsmeyer–Peppas Model | ||||
|---|---|---|---|---|---|---|---|---|
| r | Slope | r | Slope | r | Slope | r | n | |
| F1 | 0.962 | 10.02 | 0.98 | −0.21 | 0.992 | 31.22 | 0.996 | 0.37 |
| F2 | 0.96 | 14.09 | 0.99 | −0.24 | 0.992 | 36.46 | 0.995 | 0.39 |
| F3 | 0.973 | 10.79 | 0.97 | −0.28 | 0.992 | 32.74 | 0.995 | 0.31 |
| F4 | 0.91 | 11.19 | 0.91 | −0.19 | 0.965 | 35.3 | 0.985 | 0.393 |
| F5 | 0.96 | 11.77 | 0.84 | −0.20 | 0.991 | 36.41 | 0.98 | 0.429 |
| F6 | 0.954 | 11.28 | 0.968 | −0.19 | 0.986 | 34.62 | 0.969 | 0.580 |
| F7 | 0.971 | 11.46 | 0.99 | −0.2 | 0.994 | 34.94 | 0.995 | 0.354 |
| F8 | 0.946 | 9.457 | 0.98 | −0.1 | 0.981 | 29.2 | 0.982 | 0.387 |
| F9 | 0.974 | 12.84 | 0.979 | −0.12 | 0.992 | 38.33 | 0.987 | 0.831 |
| Independent Factors | Low Level (−1) | Middle (0) | High Level (+1) | ||||||
|---|---|---|---|---|---|---|---|---|---|
| X1: Chitosan% | 0.5 | 0.75 | 1 | ||||||
| X2: Sodium Alginate% | 0.25 | 0.5 | 0.75 | ||||||
| Film composition | F1 | F2 | F3 | F4 | F5 | F6 | F7 | F8 | F9 |
| SSD | 1% | ||||||||
| Chitosan | 0.5 | 0.75 | 0.75 | 1 | 0.75 | 0.5 | 1 | 1 | 0.5 |
| Sodium Alginate | 0.75 | 0.75 | 0.25 | 0.75 | 0.5 | 0.25 | 0.25 | 0.5 | 0.5 |
| Ammonia solution | 1 mL | ||||||||
| Propylene Glycol % | 5% | ||||||||
| Score | Criteria |
|---|---|
| 1–3 | No to minimal cell accumulation. No granulation tissue or epithelial travel. |
| 4–6 | Thin, immature granulation that is dominated by inflammatory cells but has few fibroblasts, capillaries or collagen deposition. Minimal epithelial migration. |
| 7–9 | Moderately thick granulation tissue can range from being dominated by inflammatory cells to more fibroblasts and collagen deposition. Extensive neovascularization. Epithelium can range from minimal to moderate migration. |
| 10–12 | Thick, vascular granulation tissue dominated by fibroblasts and extensive collagen deposition. Epithelium partially to completely covering the wound. |
Disclaimer/Publisher’s Note: The statements, opinions and data contained in all publications are solely those of the individual author(s) and contributor(s) and not of MDPI and/or the editor(s). MDPI and/or the editor(s) disclaim responsibility for any injury to people or property resulting from any ideas, methods, instructions or products referred to in the content. |
© 2023 by the authors. Licensee MDPI, Basel, Switzerland. This article is an open access article distributed under the terms and conditions of the Creative Commons Attribution (CC BY) license (https://creativecommons.org/licenses/by/4.0/).
Share and Cite
Alshora, D.; Ashri, L.; Alfaraj, R.; Alhusaini, A.; Mohammad, R.; Alanaze, N.; Ibrahim, M.; Badran, M.M.; Bekhit, M.; Alsaif, S.; et al. Formulation and In Vivo Evaluation of Biofilm Loaded with Silver Sulfadiazine for Burn Healing. Gels 2023, 9, 855. https://doi.org/10.3390/gels9110855
Alshora D, Ashri L, Alfaraj R, Alhusaini A, Mohammad R, Alanaze N, Ibrahim M, Badran MM, Bekhit M, Alsaif S, et al. Formulation and In Vivo Evaluation of Biofilm Loaded with Silver Sulfadiazine for Burn Healing. Gels. 2023; 9(11):855. https://doi.org/10.3390/gels9110855
Chicago/Turabian StyleAlshora, Doaa, Lubna Ashri, Rihaf Alfaraj, Ahlam Alhusaini, Raeesa Mohammad, Nawal Alanaze, Mohamed Ibrahim, Mohamed M. Badran, Mounir Bekhit, Shaikha Alsaif, and et al. 2023. "Formulation and In Vivo Evaluation of Biofilm Loaded with Silver Sulfadiazine for Burn Healing" Gels 9, no. 11: 855. https://doi.org/10.3390/gels9110855
APA StyleAlshora, D., Ashri, L., Alfaraj, R., Alhusaini, A., Mohammad, R., Alanaze, N., Ibrahim, M., Badran, M. M., Bekhit, M., Alsaif, S., Alagili, M., Ali, R. A., & Jreebi, A. (2023). Formulation and In Vivo Evaluation of Biofilm Loaded with Silver Sulfadiazine for Burn Healing. Gels, 9(11), 855. https://doi.org/10.3390/gels9110855








